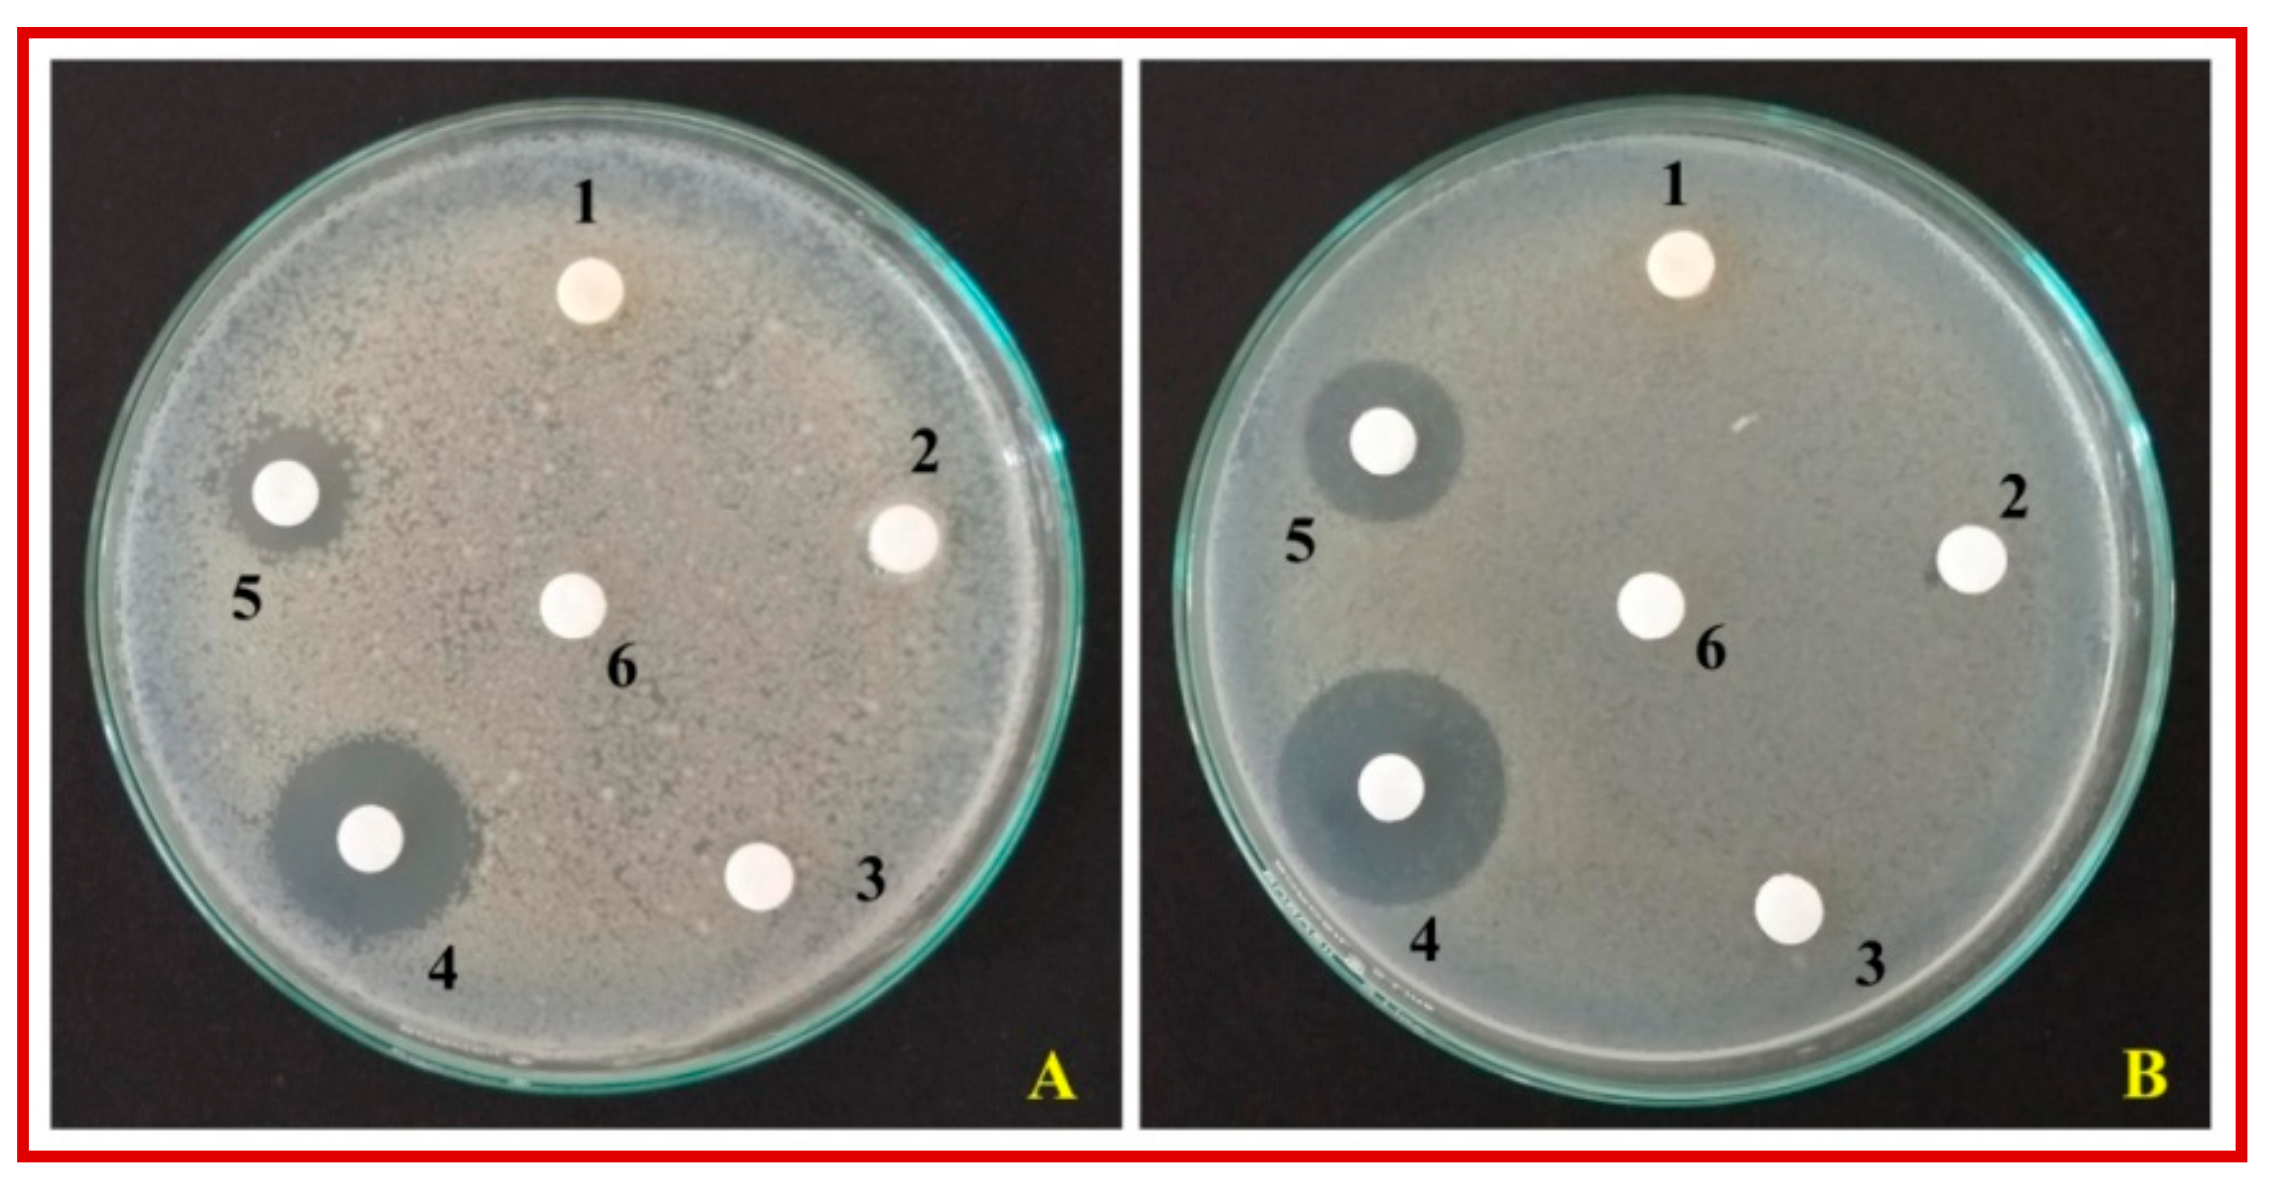
Biomolecules 10 00336 g007 Biomolecules 10 00336 g007

Cinnamomum verum Bark Extract Mediated Green Synthesis of ZnO Nanoparticles and Their Antibacterial Potentiality
Abstract
1. Introduction
2. Materials and Synthesis Method
2.1. Collection of Plant Material and Green Synthesis of ZnO-NPs
2.2. Characterization of ZnO NPs
2.3. Antibacterial Activity
2.3.1. Disc Diffusion Method
2.3.2. Minimum Inhibitory Concentration (MIC)
2.3.3. Morphological Evaluation of Bacterial Cells by Fluorescence Microscopy
2.4. Statically Analysis
3. Results and Discussion
3.1. Collection of Plant Material and Green Synthesis of ZnO-NPs
3.2. Characterization of ZnO NPs
3.3. Antibacterial Activity
3.3.1. Disc Diffusion Method
3.3.2. Minimum Inhibitory Concentration (MIC)
3.3.3. Morphological Evaluation of Bacterial Cells by Fluorescence Microscopy
4. Conclusions
Supplementary Materials
Author Contributions
Funding
Acknowledgments
Conflicts of Interest
References
- Hajipour, M.J.; Fromm, K.M.; Ashkarran, A.A.; De Aberasturi, D.J.; De Larramendi, I.R.; Lu, J.; Serpooshan, V.; Parak, W.J.; Mahmoudi, M. Antibacterial properties of nanoparticles. Trends Biotechnol. 2012, 30, 499–511. [Google Scholar] [CrossRef] [PubMed]
- Maynard, A.D.; Warheit, D.B.; Philbert, M.A. The New Toxicology of Sophisticated Materials: Nanotoxicology and Beyond. Toxicol. Sci. 2011, 120. [Google Scholar] [CrossRef] [PubMed]
- Ji, J.; Zhang, W. Bacterial behaviors on polymer surfaces with organic and inorganic antimicrobial compounds. J. Biomed. Mater. Res. 2008, 88, 448–453. [Google Scholar] [CrossRef] [PubMed]
- Goharshadi, E.K.; Ding, Y.; Jorabchi, M.N.; Nancarrow, P. Ultrasound-assisted green synthesis of nanocrystalline ZnO in the ionic liquid [hmim][NTf2]. Ultrason. Sonochem. 2009, 16, 120–123. [Google Scholar] [CrossRef] [PubMed]
- Sharifalhoseini, Z.; Entezari, M.H.; Jalal, R. Direct and indirect sonication affect differently the microstructure and the activity. Ultrason. Sonochem. 2015, 27, 466–473. [Google Scholar] [CrossRef]
- Abbasalipourkabir, R.; Moradi, H.; Zarei, S.; Asadi, S.; Salehzadeh, A.; Ghafourikhosroshahi, A.; Mortazavi, M.; Ziamajidi, N. Toxicity of zinc oxide nanoparticles on adult male Wistar rats. Food Chem. Toxicol. 2015, 84, 154–160. [Google Scholar] [CrossRef]
- Hanagata, N.; Morita, H. Calcium ions rescue human lung epithelial cells from the toxicity of zinc oxide nanoparticles. J. Toxicol. Sci. 2015, 40, 625–635. [Google Scholar] [CrossRef]
- Skwarek, E. Surfactants decrease the toxicity of ZnO, TiO2 and Ni nanoparticles to Daphnia magna. Ecotoxicology 2015, 24, 1923–1932. [Google Scholar]
- Senapati, V.A.; Kumar, A.; Gupta, G.S.; Pandey, A.K.; Dhawan, A. ZnO nanoparticles induced inflammatory response and genotoxicity in human blood cells: A mechanistic approach. Food Chem. Toxicol. 2015, 85, 61–70. [Google Scholar] [CrossRef]
- Matinise, N.; Fuku, X.G.; Kaviyarasu, K.; Mayedwa, N.; Maaza, M. Applied Surface Science ZnO nanoparticles via Moringa oleifera green synthesis: Physical properties & mechanism of formation. Appl. Surf. Sci. 2017, 406, 339–347. [Google Scholar]
- Guo, B.-L.; Han, P.; Guo, L.-C.; Cao, Y.-Q.; Li, A.-D.; Kong, J.-Z.; Zhai, H.; Wu, D. The Antibacterial Activity of Ta-doped ZnO Nanoparticles. Nanoscale Res. Lett. 2015, 10, 1047. [Google Scholar] [CrossRef] [PubMed]
- Méndez-Medrano, M.G.; Kowalska, E.; Lehoux, A.; Herissan, A.; Ohtani, B.; Bahena, D.; Briois, V.; Colbeau-Justin, C.; Rodriguez-Lopez, J.; Remita, H. Surface Modification of TiO2 with Ag Nanoparticles and CuO Nanoclusters for Application in Photocatalysis. J. Phys. Chem. C 2016, 120, 5143–5154. [Google Scholar] [CrossRef]
- Day, R.; Mankin, M.N.; Lieber, C.M. Plateau–Rayleigh Crystal Growth of Nanowire Heterostructures: Strain-Modified Surface Chemistry and Morphological Control in One, Two, and Three Dimensions. Nano Lett. 2016, 16, 2830–2836. [Google Scholar] [CrossRef] [PubMed]
- Piella, J.; Bastus, N.G.; Puntes, V. Size-Controlled Synthesis of Sub-10-nanometer Citrate-Stabilized Gold Nanoparticles and Related Optical Properties. Chem. Mater. 2016, 28, 1066–1075. [Google Scholar] [CrossRef]
- Kim, E.; Kim, M.; Im, N.; Park, S.N. Photolysis of the organic UV filter, avobenzone, combined with octyl methoxycinnamate by nano-TiO2 composites. J. Photochem. Photobiol. B Boil. 2015, 149, 196–203. [Google Scholar] [CrossRef] [PubMed]
- Lee, G.-H. Morphology and luminescence properties of ZnO micro/nanostructures synthesized via thermal evaporation of Zn–Mg mixtures. Ceram. Int. 2015, 41, 8475–8480. [Google Scholar] [CrossRef]
- Inguva, S.; Gray, C.; McGlynn, E.; Mosnier, J.-P. Origin of the 3.331 eV emission in ZnO nanorods: Comparison of vapour phase transport and pulsed laser deposition grown nanorods. J. Lumin- 2016, 175, 117–121. [Google Scholar] [CrossRef]
- Chebil, W.; Boukadhaba, M.; Fouzri, A. Epitaxial growth of ZnO on quartz substrate by sol-gel spin-coating method. Superlattices Microstruct. 2016, 95, 48–55. [Google Scholar] [CrossRef]
- Sreedhar, A.; Kwon, J.H.; Yi, J.; Kim, J.S.; Gwag, J.S. Enhanced photoluminescence properties of Cu-doped ZnO thin films deposited by simultaneous RF and DC magnetron sputtering. Mater. Sci. Semicond. Process. 2016, 49, 8–14. [Google Scholar] [CrossRef]
- Shewale, P.; Yu, Y.S. The effects of pulse repetition rate on the structural, surface morphological and UV photodetection properties of pulsed laser deposited Mg-doped ZnO nanorods. Ceram. Int. 2016, 42, 7125–7134. [Google Scholar] [CrossRef]
- Ansari, M.A.; Alzohairy, M.A. One-Pot Facile Green Synthesis of Silver Nanoparticles Using Seed Extract of Phoenix dactylifera and Their Bactericidal Potential against MRSA. Evidence-Based Complement. Altern. Med. 2018, 2018, 1–9. [Google Scholar] [CrossRef] [PubMed]
- Ali, S.G.; Ansari, M.A.; Khan, H.M.; Jalal, M.; Mahdi, A.A.; Cameotra, S.S. Antibacterial and Antibiofilm Potential of Green Synthesized Silver Nanoparticles against Imipenem Resistant Clinical Isolates of P. aeruginosa. BioNanoScience 2018, 8, 544–553. [Google Scholar] [CrossRef]
- Chen, P.; Sun, J.; Ford, P. Differentiation of the Four Major Species of Cinnamons (C. burmannii, C. verum, C. cassia, and C. loureiroi) Using a Flow Injection Mass Spectrometric (FIMS) Fingerprinting Method. J. Agric. Food Chem. 2014, 62, 2516–2521. [Google Scholar] [CrossRef] [PubMed]
- Suresh, D.; Shobharani, R.M.; Nethravathi, P.C.; Kumar, M.P.; Nagabhushana, H.; Sharma, S.C. Artocarpus gomezianus aided green synthesis of ZnO nanoparticles: Luminescence, photocatalytic and antioxidant properties. Spectrochim. Acta - Part. A Mol. Biomol. Spectrosc. 2015, 141, 128–134. [Google Scholar] [CrossRef] [PubMed]
- Ramesh, M.; Anbuvannan, M.; Viruthagiri, G. Green synthesis of ZnO nanoparticles using Solanum nigrum leaf extract and their antibacterial activity. Spectrochim. Acta Part A Mol. Biomol. Spectrosc. 2015, 136, 864–870. [Google Scholar] [CrossRef]
- Azeredo, C.M.O.; Santos, T.G.; Helena, B.; Noronha, L.D.; Maia, S. In vitro biological evaluation of eight different essential oils against Trypanosoma cruzi, with emphasis on Cinnamomum verum essential oil. BMC Complement. Altern. Med. 2014, 14, 309–317. [Google Scholar] [CrossRef]
- Mathew, S.; Abraham, T.E. Studies on the antioxidant activities of cinnamon (Cinnamomum verum) bark extracts, through various in vitro models. Food Chem. 2006, 94, 520–528. [Google Scholar] [CrossRef]
- Rattanachaikunsopon, P.; Phumkhachorn, P. Potential of cinnamon (Cinnamomum verum) oil to control Streptococcus iniae infection in tilapia (Oreochromis niloticus). Fish. Sci. 2010, 76, 287–293. [Google Scholar] [CrossRef]
- Ahmad, M.; Lim, C.P.; Akowuah, G.A.; Ismail, N.N.; Hashim, M.A.; Hor, S.Y.; Ang, L.F.; Yam, M.F. Safety assessment of standardised methanol extract of Cinnamomum burmannii. Phytomedicine 2013, 20, 1124–1130. [Google Scholar] [CrossRef]
- Kot, B.; Wicha, J.; Piechota, M.; Wolska, K.; Gruzewska, A. Antibiofilm activity of trans-cinnamaldehyde, p-coumaric, and ferulic acids on uropathogenic Escherichia coli. Turk. J. Med. Sci. 2015, 45, 919–924. [Google Scholar] [CrossRef]
- Williams, A.R.; Ramsay, A.; Hansen, T.V.; Ropiak, H.M.; Mejer, H.; Nejsum, P.; Mueller-Harvey, I.; Thamsborg, S.M. Anthelmintic activity of trans - cinnamaldehyde and A- and B-type proanthocyanidins derived from cinnamon (Cinnamomum verum). Sci. Rep. 2015, 5, 14791. [Google Scholar] [CrossRef]
- Zhang, J.-H.; Liu, L.-Q.; He, Y.-L.; Kong, W.-J.; Huang, S.-A. Cytotoxic effect of trans-cinnamaldehyde on human leukemia K562 cells. Acta Pharmacol. Sin. 2010, 31, 861–866. [Google Scholar] [CrossRef]
- Bang, K.; Lee, D.; Park, H.; Rhee, Y. Inhibition of Fungal Cell Wall Synthesizing Enzymes by trans -Cinnamaldehyde. Biosci. Biotechnol. Biochem. 2014, 8451, 1061–1063. [Google Scholar]
- Lakshmeesha, T.R.; Sateesh, M.K.; Prasad, B.D.; Sharma, S.C.; Kavyashree, D.; Chandrasekhar, M.; Bhushana, N. Reactivity of Crystalline ZnO Superstructures against Fungi and Bacterial Pathogens: Synthesized Using Nerium oleander Leaf Extract. Cryst. Growth Des. 2014, 14, 4068–4079. [Google Scholar] [CrossRef]
- CLSI Document M02-A11. Clinical and Laboratory Standards Institute (CLSI). Performance Standards for Antimicrobial Disk Susceptibility Tests, Approved Standard, 7th ed.; CLSI document M02-A11; Clinical and Laboratory Standards Institute: Wayne, PA, USA, 2012. [Google Scholar]
- Clinical and Laboratory Standards Institute (CLSI). Methods for Dilution Antimicrobial Susceptibility Tests for Bacteria that Grow Aerobically, Approved Standard, 9th ed.; CLSI document M07-A9; Clinical and Laboratory Standards Institute: Wayne, PA, USA, 2012. [Google Scholar]
- Chen, X.; Huang, X.; Zheng, C.; Liu, Y.; Xu, T.; Liu, J. Preparation of different sized nano-silver loaded on functionalized graphene oxide with highly effective antibacterial properties. J. Mater. Chem. B 2015, 3, 7020–7029. [Google Scholar] [CrossRef]
- Kumar, N.K.; Murali, M.; Satish, A.; Singh, S.B.; Gowtham, H.G.; Mahesh, H.M.; Lakshmeesha, T.R.; Amruthesh, K.N.; Jagannath, S. Bioactive and biocompatible nature of green synthesized zinc oxide nanoparticles from Simarouba glauca DC.: An endemic plant to western Ghats, India. J. Cluster Sci. 2020, 31, 523–534. [Google Scholar] [CrossRef]
- Anandan, S.; Mahadevamurthy, M.; Ansari, M.A.; Alzohairy, M.A.; Alomary, M.N.; Farha Siraj, S.; HaluguddeNagaraja, S.; Chikkamadaiah, M.; Thimappa Ramachandrappa, L.; Naguvanahalli Krishnappa, H.K.; et al. Biosynthesized ZnO-NPs from Morus indica Attenuates Methylglyoxal-Induced Protein Glycation and RBC Damage: In-Vitro, In-Vivo and Molecular Docking Study. Biomolecules 2019, 9, 882. [Google Scholar] [CrossRef]
- Seshadri, R.; Rao, A.C.N.R.; Muller, A.; Cheetham, A.K. (Eds.) The Chemistry of Nanomaterials; Wiley-VCH Verlag GmbH: Weinheim, Germany, 2004; Volume 1, p. 94. [Google Scholar]
- Sirelkhatim, A.; Mahmud, S.; Seeni, A.; Kaus, N.H.M.; Ann, L.C.; Bakhori, S.K.M.; Hasan, H.; Mohamad, D. Review on zinc oxide nanoparticles: Antibacterial activity and toxicity mechanism. Nano-Micro Lett. 2015, 7, 219–242. [Google Scholar] [CrossRef]
- Baek, Y.-W.; An, Y.-J. Microbial toxicity of metal oxide nanoparticles (CuO, NiO, ZnO, and Sb2O3) to Escherichia coli, Bacillus subtilis, and Streptococcus aureus. Sci. Total. Environ. 2011, 409, 1603–1608. [Google Scholar] [CrossRef]
- Emami-Karvani, Z.; Chehrazi, P. Antibacterial activity of ZnO nanoparticle on gram-positive and gram-negative bacteria. Afr. J. Microbiol. Res. 2011, 12, 1368–1373. [Google Scholar]
- Azam, A.; Ahmed, A.S.; Oves, M.; Khan, M.S.; Habib, S.S.; Memic, A. Antimicrobial activity of metal oxide nanoparticles against Gram-positive and Gram-negative bacteria: A comparative study. Int. J. Nanomed. 2012, 7, 6003–6009. [Google Scholar] [CrossRef] [PubMed]
- Mirhosseini, M.; Firouzabadi, F.B. Antibacterial activity of zinc oxide nanoparticle suspensions on food-borne pathogens. Int. J. Dairy Technol. 2013, 2, 291–295. [Google Scholar] [CrossRef]
- Lindsay, J.A.; Foster, S.J. zur: A Zn2+-responsive regulatory element of Staphylococcus aureus. The GenBank accession number for the sequence reported in this paper is AF101263. Microbiology 2001, 5, 1259–1266. [Google Scholar] [CrossRef] [PubMed]
- Brayner, R.; Ferrari-Iliou, R.; Brivois, N.; Djediat, S.; Benedetti, M.F.; Fievet, F. Toxicological impact studies based on Escherichia coli bacteria in ultrafine ZnO nanoparticles colloidal medium. Nano Lett. 2006, 4, 866–870. [Google Scholar] [CrossRef] [PubMed]
- Outten, C.; O’Halloran, A.T.V. Femtomolar Sensitivity of Metalloregulatory Proteins Controlling Zinc Homeostasis. Science 2001, 292, 2488–2492. [Google Scholar] [CrossRef] [PubMed]
- Reddy, K.M.; Feris, K.; Bell, J.; Wingett, D.G.; Hanley, C.; Punnoose, A. Selective toxicity of zinc oxide nanoparticles to prokaryotic and eukaryotic systems. Appl. Phys. Lett. 2007, 90, 2139021–2139023. [Google Scholar] [CrossRef]
- Mahendra, C.; Murali, M.; Manasa, G.; Ponnamma, P.; Abhilash, M.R.; Lakshmeesha, T.R.; Satish, A.; Amruthesh, K.N.; Sudarshana, M.S. Antibacterial and antimitotic potential of bio-fabricated zinc oxide nanoparticles of Cochlospermum religiosum (L.). Microb. Pathog. 2017, 110, 620–629. [Google Scholar] [CrossRef]
- Padmavathy, N.; Vijayaraghavan, R. Enhanced bioactivity of ZnO nanoparticles-An antimicrobial study. Sci. Technol. Adv. Mat. 2008, 3, 035004. [Google Scholar] [CrossRef]
- Elumalai, K.; Velmurugan, S. Green synthesis, characterization and antimicrobial activities of zinc oxide nanoparticles from the leaf extract of Azadirachta indica (L.). Appl. Surf. Sci. 2015, 345, 329e336. [Google Scholar] [CrossRef]
- Nakkala, J.R.; Mata, R.; Gupta, A.K.; Sadras, S.R. Biological activities of green silver nanoparticles synthesized with Acorous calamus rhizome extract. Eur. J. Med. Chem. 2014, 85, 784–794. [Google Scholar] [CrossRef]
- Hameed, H.; Karthikeyan, C.; Ahamed, A.P.; Thajuddin, N.; Alharbi, N.S.; Alharbi, S.A.; Ravi, G. In vitro antibacterial activity of ZnO and Nd doped ZnO nanoparticles against ESBL producing Escherichia coli and Klebsiella pneumoniae. Sci. Rep. 2016, 6, 24312. [Google Scholar] [CrossRef] [PubMed]
- Ba-Abbad, M.; Takriff, M.S.; Benamor, A.; Mahmoudi, E.; Mohammad, A.W. Arabic gum as green agent for ZnO nanoparticles synthesis: Properties, mechanism and antibacterial activity. J. Mater. Sci. Mater. Electron. 2017, 4, 31–12107. [Google Scholar] [CrossRef]
- Moghaddam, A.B.; Moniri, M.; Azizi, S.; Rahim, R.A.; Bin Ariff, A.; Saad, W.Z.; Namvar, F.; Navaderi, M.; Mohamad, R. Biosynthesis of ZnO Nanoparticles by a New Pichia kudriavzevii Yeast Strain and Evaluation of their Antimicrobial and Antioxidant Activities. Molecules 2017, 22, 872. [Google Scholar] [CrossRef] [PubMed]
- Singh, A.K.; Pal, P.; Tomar, M.; Yadav, T.P.; Gupta, V.; Singh, S.P. Green synthesis, characterization and antimicrobial activity of zinc oxide quantum dots using Eclipta alba. Mater. Chem. Phys. 2018, 203, 40–48. [Google Scholar] [CrossRef]
- Jeyabharathi, S.; Kalishwaralal, K.; Sundar, K.; Muthukumaran, A. Synthesis of zinc oxide nanoparticles (ZnONPs) by aqueous extract of Amaranthus caudatus and evaluation of their toxicity and antimicrobial activity. Mater. Lett. 2017, 209, 295–298. [Google Scholar] [CrossRef]
- Dobrucka, R. Biosynthesis and antibacterial activity of ZnO nanoparticles using Trifolium pratense flower extract. Saudi J. Biol. Sci. 2016, 23, 517–523. [Google Scholar] [CrossRef]
- Supraja, N.; Prasad, T.N.V.K.V.; Dhanesh, A.; Anbumani, D. Synthesis, characterization and evaluation of antimicrobial efficacy and brine shrimp lethality assay of Alstonia scholaris stem bark extract mediated ZnONPs. Biochem. Biophys. Rep. 2018, 14, 69–77. [Google Scholar] [CrossRef]
- Patil, B.N.; Taranath, T.C. Limonia acidissima L. leaf mediated synthesis of zinc oxide nanoparticles: A potent tool against Mycobacterium tuberculosis. Int. J. Mycobacteriol. 2016, 5, 197–204. [Google Scholar] [CrossRef]
- Ali, M.; Kim, B.; Belfield, K.D.; Norman, D.; Brennan, M.; Ali, G.S. Green synthesis and characterization of silver nanoparticles using Artemisia absinthium aqueous extract — A comprehensive study. Mater. Sci. Eng. C 2016, 58, 359–365. [Google Scholar] [CrossRef]
- Suresh, D.; Nethravathi, P.; Udayabhanu; Rajanaika, H.; Bhushana, N.; Sharma, S. Green synthesis of multifunctional zinc oxide (ZnO) nanoparticles using Cassia fistula plant extract and their photodegradative, antioxidant and antibacterial activities. Mater. Sci. Semicond. Process. 2015, 31, 446–454. [Google Scholar] [CrossRef]
- Bhuyan, T.; Mishra, K.; Khanuja, M.; Prasad, R. Biosynthesis of zinc oxide nanoparticles from Azadirachta indica for antibacterial and photocatalytic applications. Mater. Sci. Semicond. Process. 2015, 32, 55–61. [Google Scholar] [CrossRef]
- Ambika, S.; Sundrarajan, M. Plant-extract mediated synthesis of ZnO nanoparticles using Pongamiapinnata and their activity against pathogenic bacteria. Adv. Powder Technol. 2015, 26, 1–6. [Google Scholar]
- Janaki, A.C.; Sailatha, E.; Gunasekaran, S. Synthesis, characteristics and antimicrobial activity of ZnO nanoparticles. Spectrochim. Acta Part A Mol. Biomol. Spectrosc. 2015, 144, 17–22. [Google Scholar] [CrossRef] [PubMed]
- Jalal, M.; Ansari, M.A.; Ali, S.G.; Khan, H.M.; Rehman, S. Anticandidal activity of bioinspired ZnO NPs: Effect on growth, cell morphology and key virulence attributes of Candida species. Artif. Cells Nanomed. Biotechnol. 2018, 46, 912–925. [Google Scholar] [CrossRef] [PubMed]
- Murali, M.; Mahendra, C.; Nagabhushan; Rajashekar, N.; Sudarshana, M.; Raveesha, K.; Amruthesh, K. Antibacterial and antioxidant properties of biosynthesized zinc oxide nanoparticles from Ceropegia candelabrum L. An endemic species. Spectrochim. Acta Part A Mol. Biomol. Spectrosc. 2017, 179, 104–109. [Google Scholar] [CrossRef] [PubMed]

| Compound | Lattice Parameters | Crystallite Size in nm | Micro Stress 𝞮hkl(103)Nm−2 | Energy Bandgap (Eg) in eV | |||
|---|---|---|---|---|---|---|---|
| a (Å) | b (Å) | V(Å)3 | D-S Approach | Williamson-Hall Approach | |||
| ZnO(a) | 2.649 | 3.666 | 33.714 | 40 | 42 | 29.77 | 3.25 |
| ZnO(b) | 3.104 | 4.073 | 34.232 | 36 | 39 | 25.06 | 3.27 |
| ZnO(c) | 3.105 | 4.756 | 41.151 | 33 | 36 | 29.02 | 3.27 |
| ZnO(d) | 3.103 | 4.072 | 34.265 | 30 | 31 | 30.97 | 3.28 |
| ZnO(e) | 3.098 | 4.063 | 34.011 | 42 | 48 | 39.77 | 3.28 |
| Test Samples | Zone if Inhibition (mm) | MIC (µg mL−1) | ||
|---|---|---|---|---|
| S. aureus | E. coli | S. aureus | E. coli | |
| Plant Extract | NA | NA | NA | NA |
| Hexane | NA | NA | NA | NA |
| ZnO-NPs(c) | 16.75 ± 0.47 | 13.25 ± 0.75 | 62.5 | 125 |
| Hexane + Zn(NO3)2 6H2O | NA | NA | NA | NA |
| Streptomycin | 24.25 ± 0.62 | 22.00 ± 0.40 | 15.62 | 15.62 |
| Sterile Distilled Water | NA | NA | NA | NA |
| Nanoparticles | Bacteria | Zone of Inhibition/MIC/MBC | Plant | Method of Synthesis | Crystal Size | Morphology | Reference |
|---|---|---|---|---|---|---|---|
| ZnO NPs | Escherichia coli | 4.2 mm | Arabic gum | Sol–gel method | 16 nm | Spherical | [55] |
| ZnO NPs | B. subtilis S. epidermidis S. aureus E. coli S. marcescens | 8 mm 16 mm 9 mm 9 mm 8.5 mm | Pichia kudriavzevii | Extracellular Synthesis | ~10–61 nm | hexagonal wurtzite | [56] |
| ZnO quantum dots | E. coli | 15.69 mm | Eclipta alba | Solution combustion method | ~6 nm | Spherical | [57] |
| ZnO NPs | S. epidermidis E. aerogenes | 14 mm 9 mm | Amaranthus caudatus | Solution combustion method | - | Spherical | [58] |
| ZnO NPs | S. aureus E. coli P. aeruginosa | 31 mm 31 mm 23 mm | Trifoliumpratense | Solution combustion method | 190 nm | Agglomerated | [59] |
| ZnO NPs | S. thalpophilum Ochrobactrum sp. Achromobacter sp. Sphingobacteriumsp. Acinetobacter sp. Ochrobactrum sp. | 1.5 mm 2.2 mm 1.2 mm 3 mm 1.7 mm 4 mm | Boswelliaovalifoliolata | Filtration method | 20.3 nm | Spherical | [60] |
| ZnO NPs | M. tuberculosis | 12.5 µg mL−1 (MIC) | Limoniaacidissima | Solution combustion method | 12–53 nm | Spherical | [61] |
| ZnO NPs | E. coli S. aureus P. aeruginosa | 2200 µg mL−1 (MIC) 2400 µg mL−1 (MBC) | Aloe vera | Solution combustion method | 8–18 nm | Spherical, oval and hexagonal | [62] |
| ZnO NPs | S. aureus S. paratyphi V. cholerae E. coli | 18 mm 6 mm 11 mm 7 mm | Solanum nigrum | Solution combustion method | 29.79 nm | Quasi-spherical | [25] |
| ZnO NPs | K. aerogenes E. coli P. desmolyticum S. aureus | 9.67 mm 4.67 mm 4 mm 4.67 mm | Cassia fistula | Solution combustion method | 5–15 nm | Hexagonal Wurtzite structure | [63] |
| ZnO NPs | S. aureus, S. pyogenes E. coli | 100 µg mL−1 (MIC) | Azadirachtaindica | Filtration | 9.6–25.5 nm | Spherical | [64] |
| ZnO NPs | S. aureus E. coli | 29 mm 25 mm | Pongamiapinnata | Solution combustion method | 100 nm | Spherical | [65] |
| ZnO NPs | S. aureus C. ablicans | 10 mm 10 mm | Zingiberofficinale | Solution combustion method | 23–25 nm | Spherical | [66] |
| ZnO NPs | S. aureus E. coli | 62.5 µg mL−1 (MIC) and 125 µg mL−1 (MIC) | C. verum | Green method | ~45 nm | Hexagonal Wurtzite | Present paper |
| ZnO NPs | C. albicans | 250 µg mL−1 (MIC) | Crinum latifolium | Green method | 10–30 nm | hexagonal and spherical | [67] |
| ZnO-NPs | S. aureus, B. subtilis, E. coli and S. typhi | 19–22 mm | C. candalebrum | Green method | 12–35 nm | Hexagonal Wurtzite | [68] |
© 2020 by the authors. Licensee MDPI, Basel, Switzerland. This article is an open access article distributed under the terms and conditions of the Creative Commons Attribution (CC BY) license (http://creativecommons.org/licenses/by/4.0/).
Share and Cite
Ansari, M.A.; Murali, M.; Prasad, D.; Alzohairy, M.A.; Almatroudi, A.; Alomary, M.N.; Udayashankar, A.C.; Singh, S.B.; Asiri, S.M.M.; Ashwini, B.S.; et al. Cinnamomum verum Bark Extract Mediated Green Synthesis of ZnO Nanoparticles and Their Antibacterial Potentiality. Biomolecules 2020, 10, 336. https://doi.org/10.3390/biom10020336
Ansari MA, Murali M, Prasad D, Alzohairy MA, Almatroudi A, Alomary MN, Udayashankar AC, Singh SB, Asiri SMM, Ashwini BS, et al. Cinnamomum verum Bark Extract Mediated Green Synthesis of ZnO Nanoparticles and Their Antibacterial Potentiality. Biomolecules. 2020; 10(2):336. https://doi.org/10.3390/biom10020336
Chicago/Turabian StyleAnsari, Mohammad Azam, Mahadevamurthy Murali, Daruka Prasad, Mohammad A. Alzohairy, Ahmad Almatroudi, Mohammad N. Alomary, Arakere Chunchegowda Udayashankar, Sudarshana Brijesh Singh, Sarah Mousa Maadi Asiri, Bagepalli Shivaram Ashwini, and et al. 2020. "Cinnamomum verum Bark Extract Mediated Green Synthesis of ZnO Nanoparticles and Their Antibacterial Potentiality" Biomolecules 10, no. 2: 336. https://doi.org/10.3390/biom10020336
APA StyleAnsari, M. A., Murali, M., Prasad, D., Alzohairy, M. A., Almatroudi, A., Alomary, M. N., Udayashankar, A. C., Singh, S. B., Asiri, S. M. M., Ashwini, B. S., Gowtham, H. G., Kalegowda, N., Amruthesh, K. N., Lakshmeesha, T. R., & Niranjana, S. R. (2020). Cinnamomum verum Bark Extract Mediated Green Synthesis of ZnO Nanoparticles and Their Antibacterial Potentiality. Biomolecules, 10(2), 336. https://doi.org/10.3390/biom10020336






